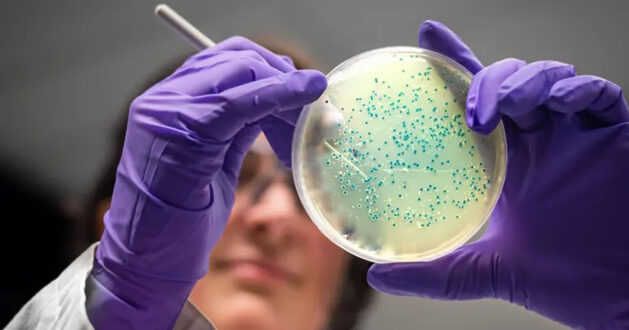

15 Ağustos 2025
Araştırmacılar, yapay zekanın ilaca dirençli gonore (belsoğukluğu) ve MRSA bakterilerini öldürebilecek iki yeni potansiyel antibiyotik icat ettiğini ortaya koydu.
İlaçlar yapay zeka tarafından atom atom tasarlandı ve laboratuvarda ve hayvanlar üzerinde yapılan testlerde, antibiyotiğe dirençli bakterileri öldürdü.
Bu iki ilacın reçete edilebilmeleri için hala yıllar sürecek geliştirme ve klinik deneyler gerekiyor.
Ancak Massachusetts Teknoloji Enstitüsü (MIT) ekibi, yapay zekanın antibiyotik keşfinde “ikinci bir altın çağ” başlatabileceğini söylüyor.